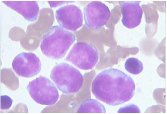

貝克曼庫爾特商貿(mào)(中國)有限公司
白金會員
已認(rèn)證

貝克曼庫爾特商貿(mào)(中國)有限公司
白金會員
已認(rèn)證
白血病是一種亞型眾多的疾病,結(jié)合形態(tài)學(xué)、免疫學(xué)、細(xì)胞遺傳學(xué)和分子生物學(xué)等因素分類不同類型,對應(yīng)的治療方法和用藥會直接影響治療效果。面對罕見白血病表現(xiàn),如何更好的做白血病亞型診斷?
本問將通過一個臨床病例詳細(xì)為您解答。
////
病史介紹:
患者男性,35 歲,已婚?;颊呷朐?5 天前發(fā)現(xiàn)胸、腹、背部等皮膚紫癜,伴發(fā)熱、頭痛,最高體溫 37.5℃,無腹痛、惡心,未就診,后因上半身出血點逐漸增多到當(dāng)?shù)蒯t(yī)院檢查,檢驗示: 白細(xì)胞 22.2×10^9/L, 血小板 34×10^9/L, 單核細(xì)胞 8.69×10^9/L, 外周血形態(tài)鏡檢: 可見原始+幼稚細(xì)胞占 91.1%。門診于 2020 年 01 月 04 日以「白細(xì)胞增高待查」收入院。
入院生命體征:體溫 36.7℃,脈搏 110 次/分,呼吸 17 次/分,血壓 140/85 mmHg,體重 77.9 Kg。
專體檢查:全身淋巴結(jié)未觸及腫大,胸骨無壓痛,呼吸運動正常,肋間隙正常,語顫正常,無胸膜摩擦感,無皮下捻發(fā)感,叩診清音,雙肺呼吸音清、無干、濕啰音,腹平坦,無腹壁靜脈曲張,無胃腸型,無蠕動波,腹式呼吸存在。臍正常、無分泌物。腹部無壓痛、反跳痛。腹部柔軟、無包塊。肝臟肋緣下未觸及。
初步檢查及診斷:
未分類原始+幼稚 88.00,白細(xì)胞計數(shù) 19.70×10^9/L ,紅細(xì)胞計數(shù) 4.02×10^12/L ,血紅蛋白 126.0 g/L ,血小板計數(shù) 39×10^9/L ,中性粒細(xì)胞百分?jǐn)?shù) 2.8%;EB 病毒陰性;凝血、尿、便常規(guī)、電解質(zhì)大致可;超聲檢查可見脾大。
骨髓涂片:
1. 取材可, 涂片可, 染色良好。髓小粒 (+), 脂肪滴 (-)。
2. 骨髓增生明顯活躍, 粒: 紅=0.50: 1。
3. 原始細(xì)胞占 90.8%, 該類細(xì)胞胞體中等大小, 類圓形, 漿量中等或偏少, 染淺蘭色, 核類圓形, 部分可見凹陷, 染色質(zhì)細(xì)致, 核仁顯隱可見。
4. 粒系受抑制, 占 0.4%。
5. 紅系受抑制, 占 0.8%。成熟紅細(xì)胞大小形態(tài)正常, 血紅蛋白充盈可。
6. 淋巴細(xì)胞比值減低, 形態(tài)正常。
7. 巨核細(xì)胞 50 個/片, 血小板散在可見。染色體正常核型。
綜上分析考慮急性白血病, 類型待定。
流式檢測方案及檢測結(jié)果:
免疫分析選用四色抗體,采用 CD45/SSC 設(shè)門??贵w組合為:





1. B 門細(xì)胞占 97.0%,CD45 表達(dá)較淋巴細(xì)胞稍弱,高表達(dá) CD7、CD123、CD56、HLA-DR、CD38、TdT,部分表達(dá) CD2、CD4,不表達(dá) CD3、CD8、CD5、CD16、CD57、CD41、CD61、CD303、CD304、CD34、cMPO、cCD79a、cCD3 和其它分化抗原,提示為異常 NK 細(xì)胞。
2. 粒細(xì)胞(C 門)占 0.6%,比例明顯減低。
3. 淋巴細(xì)胞(A 門)占 1.8%,比例減低。
……
最終診斷:
臨床診斷為****細(xì)胞白血病。
病例分析及總結(jié)思考:
****白血病是一種罕見類型的白血病,亞洲人更多見,患者多為男性。臨床表現(xiàn)為發(fā)熱、全身癥狀和白血病血象。外周血中白血病細(xì)胞可高可低,貧血、中性粒細(xì)胞減少*****
掃描下方二維碼或點擊「閱讀原文」,按引導(dǎo)提交信息后點擊「病例分享匯」-「血液科」即可查看完整診斷結(jié)果及病例分析思考。

作者簡介:

張秋堂
副主任技師,鄭州大學(xué)第一附屬醫(yī)院血液病實驗室主任,河南省實驗血液學(xué)會常委,河南省血液病理實驗診斷專業(yè)委員會副主任委員,河南省老年醫(yī)學(xué)學(xué)會檢驗醫(yī)學(xué)專業(yè)委員會副主任委員,河南省疑難血液病專家會診組成員,河南省首臺流式細(xì)胞儀操作者,擅長流式細(xì)胞術(shù)和形態(tài)的綜合診斷。
////
點擊「閱讀原文」,查看更多精彩病例、課程。注冊學(xué)員即可免費學(xué)習(xí)更多臨床病例、大咖課程!注冊用戶中,也將隨機(jī)選取 30 位,送上「鼠」于你的精美公仔!

責(zé)任編輯:杭璐
閱讀原文
最新動態(tài)
更多
手機(jī)版: